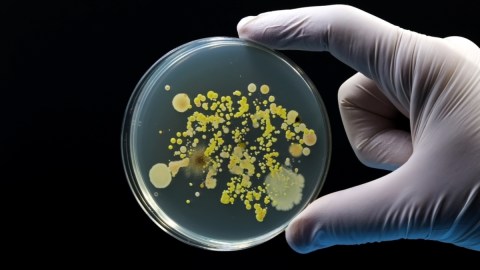

Reportan dos muertos por brote de listeria en Estados Unidos
Un brote de listeria en EE. UU. ha causado 2 muertes y 28 hospitalizaciones en 12 estados. El CDC investiga el vínculo con fiambres cortados en mostradores
La listeria es una bacteria que puede provocar enfermedades graves cuando se extiende desde el intestino a otras partes del cuerpo. Crédito: TopMicrobialStock | Shutterstock
En Estados Unidos un brote de listeria ha causado la muerte de dos personas y ha llevado a la hospitalización de 28 en 12 estados diferentes, según informaron el viernes las autoridades federales de salud. El Centro para el Control y la Prevención de Enfermedades (CDC) ha revelado que las infecciones están relacionadas con el consumo de fiambres cortados en mostradores de delicatessen.
Los casos de listeria se han registrado en una amplia región que abarca desde el Medio Oeste hasta la Costa Este del país. Esta bacteria, conocida por causar enfermedades transmitidas por alimentos, representa un riesgo significativo, especialmente para las personas embarazadas, los ancianos y aquellos con sistemas inmunitarios debilitados.

El CDC indicó que las muestras de las personas afectadas fueron recolectadas entre el 28 de mayo y el 5 de julio, y de las 18 personas entrevistadas, 16 informaron haber consumido carne cortada en lonchas, principalmente pavo, paté de hígado y jamón.
La investigación sobre el brote continúa, enfocándose en determinar qué tipos específicos de carne podrían estar contaminados. Hasta el momento, no se ha encontrado evidencia de que los embutidos envasados estén implicados en este brote.
Las muertes se produjeron en Illinois y Nueva Jersey, mientras que Nueva York reportó el mayor número de casos con siete afectados. Otros estados con casos incluyen Maryland con seis, Missouri, Virginia, Georgia y Massachusetts con dos cada uno, y Minnesota, Wisconsin, Illinois, Pensilvania y Carolina del Norte con un caso cada uno.
La listeria es una bacteria que puede provocar enfermedades graves cuando se extiende desde el intestino a otras partes del cuerpo. Los síntomas típicos de la infección suelen aparecer entre una y cuatro semanas después de ingerir alimentos contaminados, aunque en algunos casos pueden manifestarse el mismo día o hasta 70 días después. Incluyen dolores de cabeza, rigidez del cuello, confusión, pérdida del equilibrio, convulsiones, fiebre y dolores musculares.
Dado el riesgo que presenta esta infección, el CDC ha emitido recomendaciones claras para las personas en mayor riesgo. Se aconseja evitar el consumo de carnes cortadas en mostradores de delicatessen a menos que estas sean calentadas a una temperatura interna de 165 grados Fahrenheit o se sirvan muy calientes. Además, cualquier persona que haya consumido recientemente fiambres cortados en rodajas y presente síntomas de listeria debe buscar atención médica de inmediato.
Peligro de la enfermedad por listeria
La listeriosis, la enfermedad causada por la bacteria listeria, es especialmente debido a su potencial de causar complicaciones severas. En mujeres embarazadas, puede provocar abortos espontáneos, muerte fetal, parto prematuro y graves infecciones en los recién nacidos.
En los ancianos y en personas con sistemas inmunitarios comprometidos, la listeriosis puede llevar a la septicemia y meningitis, ambas condiciones que pueden ser mortales si no se tratan adecuadamente.
Las autoridades de salud están trabajando arduamente para rastrear la fuente exacta del brote. Mientras tanto, instan a los consumidores a ser precavidos y a seguir las recomendaciones de seguridad alimentaria para minimizar el riesgo de infección. Además, el CDC continúa monitoreando la situación de cerca y proporciona actualizaciones regulares a medida que se obtienen más datos de la investigación en curso.

La respuesta a este brote subraya la importancia de la seguridad alimentaria y la vigilancia continua en la producción y distribución de alimentos. La colaboración entre los funcionarios de salud pública, las autoridades reguladoras y la industria alimentaria es crucial para identificar rápidamente las fuentes de contaminación y prevenir futuros brotes.
La listeria, aunque menos común que otras bacterias transmitidas por los alimentos como la salmonella o el E. coli, sigue siendo una preocupación significativa debido a su alta tasa de mortalidad entre los infectados. Este brote actual destaca la necesidad de medidas preventivas estrictas y de una rápida respuesta ante cualquier indicio de contaminación en la cadena alimentaria.
El brote de listeria en Estados Unidos ha resultado en la pérdida de vidas y ha puesto en peligro la salud de muchas personas en varios estados. Las investigaciones continúan para determinar la fuente exacta de la contaminación, mientras las autoridades de salud pública recomiendan medidas preventivas para reducir el riesgo de infección.
Sigue leyendo: